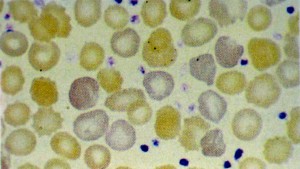
Policromasia de eritr&oacute;citos (nota-se tamb&eacute;m trombocitose)
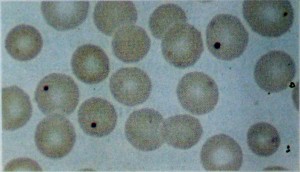
Corpos de Jolly em eritr&oacute;citos (colora&ccedil;&atilde;o de Wright&rsquo;s)

Reticulócitos
Caracteriza-se pela presença de estruturas filamentosas reticulares ou granulares em aproximadamente 0,5 a 1,5% do total de eritrócitos. Estas estruturas são distinguidas apenas se coloridas com azul de metileno, quando os eritrócitos assumem uma cor azul-esverdeada e as estruturas filamentosas ficam da cor azul-negra. Em condições patológicas, tais como anemias hemoliticas ou perdas sanguíneas agudas, os reticulócitos ficam proeminentes. Uma variante patológica é o acromorreticulócito, que contém estruturas filamentares reticulares sem corpos celulares visíveis.
Equivalentes morfológicos dos reticulócitos
Policromasia: a cor violeta vista em alguns eritrócitos após coloração de Giemsa ou de Whight’s, corresponde a um achado basofílico extremo. Assim, esta pode ser também uma regeneração (aumento de eritrócitos). A substância basofílica em eritrócitos com pontilhado basófilo e em policromasia são remanescentes contendo RNA (ribossomas) de citoplasma de proeritroblastos. Eritrócitos policromáticos, ou reticulócitos, serão sempre maiores que os normócitos, e sua membrana celular terá forma ligeiramente achatada.
Pontilhado basofílico de eritrócito: visto como um pontilhado azul-preto extremamente fino e difuso, distribuído dentro da células. É reconhecido apenas por coloração convencional de Giemsa ou de Wright’s, ou com coloração especial de Manson-Sschwartz, usando-se solução básica de azul de metileno a 1%. Eritrócitos com pontilhado basófilo raramente são encontrados no sangue normal. Sua ocorrência sempre indicará reticulocitose, sendo evidência do aumento da eritropoiese ou distúrbio na síntese de hemoglobina. O pontilhado basofílico corresponde aos conteúdos de RNA agregados aos ribossomos e se formam durante a secagem do esfregaço sanguíneo.
Produtos finais de eritropoiese
Eritrócitos: células avermelhadas, circulares, bicôncavas, tendo todas as células quase o mesmo tamanho e ainda, não possuem estruturas internas visíveis. O brilho no centro da célula é causada por sua forma bicôncava.
Outras estruturas internas dos eritrócitos
Corpos de Jolly: são remanescentes nucleares picnóticos contendo DNA, vistos nos eritrócitos sob coloração de Wright’s. Aumenta após esplenectomia, em anemias hemoliticas e anemias megaloblásticas.
Anéis de Cabot: alça patológica em forma de oclusão, encontrado em eritrócitos devido a falha na eritropoiese. Formam-se a partir de um resquício da membrana nuclear ou de parte de um fuso mitótico.
Sideroblastos ou normoblastos: (20 a 60% do total) contendo moléculas de ferritina (aproximadamente cinco moléculas por células); também chamados de siderossomos. Esta células estão ausentes na anemia ferropriva e também da anemia de corrente de infecção.

Esfregaço com coloração supravital mostrando diversos reticulócitos
Policromasia de eritrócitos (nota-se também trombocitose)

Eritrócito com pontilhado basofílico

Eritrócitos normais
Corpos de Jolly em eritrócitos (coloração de Wright’s)

Anéis de Cabot com cromatina fina em eritrócitos

Sideroblasto

Siderócito

